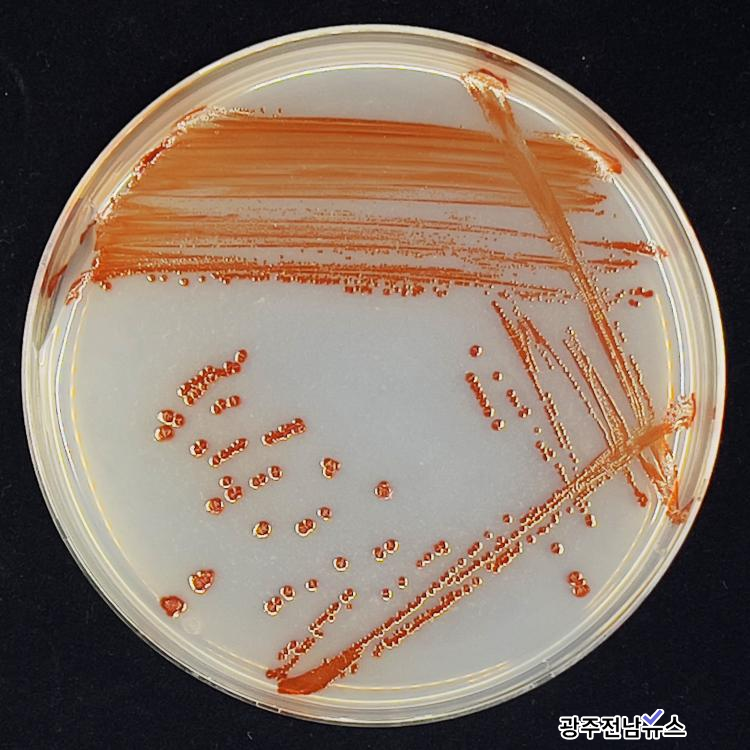

|
Ĺ ǥ źҰ ȭ ħ ߿ ƴ϶ Ŀ‧, ڿ پ о߿ Ȱǰ , ̻ Ĺ ȣ ռ, ȯ Ʈ Ĺ 忡 ġ ˷ ִ.
Ĺ ϴ ̻ پ缺 ɿ Ͽ ȣǻڿ ϰ ̹ ߴٰ .
ȣǻڿ 2023 ڻ ̻ 硤߱ ȯ ̹ Ͽ, Ĺ Ѹ ߱ ü м(whole-genome sequencing)Ͽ Ĺȣ Ͽ ռ, ü̹ ִ پ ڸ Ȯߴ.
ռϴ * ü ѱ̻ȸ(Korean Journal of Microbiology) 12ȣ Ͽ ļ м ̴.
* ε ϴ 긮(Vibrio) HNIBRBA4763 ֿ ö ϴ (Pseudomonas) HNIBRBA3361 (3 )
â ȣǻڿ ڿ ֿ ź ϳ ָ Ĺ ϸ ϴ ߱ ̻ Ȱ , ڿ Ȱ ʼ ̶͡ .
Ⱦֿ aayego@hanmail.net
2026.04.02() 10:17